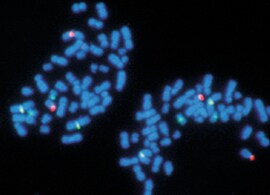
showcase.par.24730.image.0.0.1 核酸标记

Search
Search
我们在酶学、核酸化学和染料化学领域具有丰富的经验,已经开发出一系列广泛使用且倍受信赖的荧光、放射性、显色和半抗原 DNA 标记解决方案,适用于原位杂交和一般分子生物学的各种应用。
| 使用完整的 DNA 标记试剂盒、标记核酸及聚合酶创建最佳的荧光标记、生物素标记或放射性标记 DNA 探针,以供后续在原位杂交、微阵列或其他分子生物学应用中使用。 |
| 使用寡核苷酸标记试剂盒和酶创建最佳的荧光标记、生物素标记或放射性标记寡核苷酸。 |
| 使用完整的 RNA 标记试剂盒、标记核酸及聚合酶创建最佳的荧光标记、生物素标记或放射性标记 RNA 探针,以供后续在原位杂交、微阵列或其他分子生物学应用中使用。 |